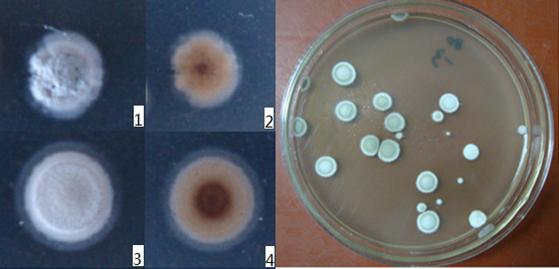

近日,由技术生物所与地方企业合作进行的“离子束诱变井冈霉素高产菌选育、发酵及制剂化”课题通过双方组织的现场验收。技术生物所微生物过程研究团队采用离子束诱变技术选育的井冈霉素高产菌株产能大幅提升,赢得企业较高评价。
此研究已历时两年,研究人员通过低能离子注入技术,以一株工业菌株——吸水链霉菌井冈变种(Streptomyces hyroscopicus var. Jingganggensis yen) SHJ001为出发菌株,经氮离子注入诱变选育得到一株高产菌株SHJ381,并对其进行了培养条件优化。
摇瓶实验结果表明,此高产菌株具有良好的遗传稳定性,发酵产物中有效成分井冈霉素A(VAL-A)含量由23000 mg/L提高到34000 mg/L,具有显著的增产效果。
井冈霉素(Jinggangmycins)是一种氨基糖苷类农用抗生素,对水稻纹枯病具有特效,具有安全、高效、对作物无药害、成本低廉、无抗药性等优点,也是目前防治水稻纹枯病药剂中最安全、最经济和最有效的微生物农药品种,近四十年来为我国水稻高产、稳产做出了重大贡献。
井冈霉素A高产菌株的选育成功为后续进一步开拓研究空间打下坚实基础,同时为合作企业的技术进步提供了重要支撑。
右图为吸水链霉菌井冈变种诱变平板及单菌落形态
左图:1、 非中心吸水型正面,2、非中心吸水型反面,3、中心吸水型正面,4、中心吸水型反面
